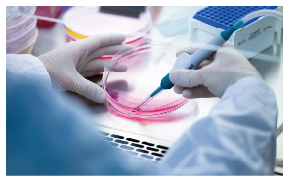

11月16日,美国卫生机构表示,计划严格限制医生推销会给患者带来巨大风险的干细胞疗法,旨在对过去缺乏监管的这一发展迅猛的医疗领域进行治理。(美联社官网)
FDA公布了一项计划,对以干细胞为基础的医疗活动加以管制。最近10年来美国各地开设的成百上千私人诊所也在监管范围之内。许多企业倡导对多种疾病采取干细胞疗法,包括关节炎、多发性硬化症,甚至阿尔茨海默病。这种疗法的价格从5千美元到5万美元不等,但很少有研究证实这种疗法的安全有效性。
多年来研究者一直呼吁打压这种做法。FDA官员说,执法活动的矛头会对准将干细胞混合物注入血液循环系统、神经系统或眼部的“行业败类”。监管人员说,这些做法给患者带来了极大的风险。
“我们会重点关注能看到产品的地方。”FDA局长Scott Gottlieb说,FDA计划酌情对诸如向疼痛的关节注射干细胞等低风险治疗方式进行监管,且监管做到灵活创新从而鼓励该领域的合法研究活动。
长期以来,干细胞被认为能让人体组织实现再生。虽然最新研究表明,干细胞最终将会被用于治疗多种使人衰弱的疾病,但目前仅为数不多的治疗过程获准使用干细胞,如通过骨髓移植获取的干细胞长期被用于治疗白血病和其他血液疾病。
大多数诊所提供成人干细胞从脂肪中提取,操作者通过脂肪抽吸收集液体,经过化学处理后注射回体内治疗各种疾病。
据今年早期刊登在《新英格兰医学杂志》的一篇文章报道,由于接受脂肪干细胞疗法,佛罗里达州的3例女性几近或彻底失明。佛罗里达州医学委员会此前因2例患者在接受静脉滴注干细胞后死亡,而撤销了1名干细胞医生的医师执照。
今年8月,FDA查办了加州2家和佛罗里达州1家干细胞治疗中心。并在随后的声明中进一步明确了干细胞属于生物类“药”,将像对待任何创新药一样,审批干细胞临床治疗方案,包括干细胞来源、储存和制备,及应用方法。








